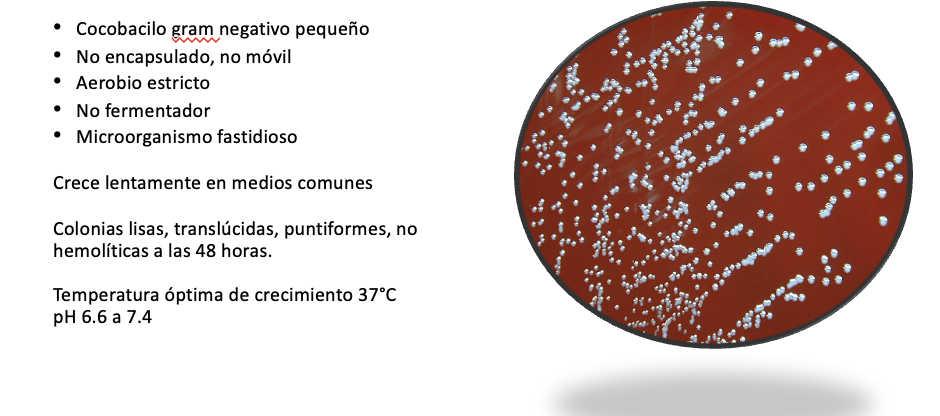

Microbiología
Especies
B. melitensis causa más frecuente de brucelosis ( Cabras)
B. abortus ( ganado vacuno)
B. suis (cerdos domésticos y salvajes)
B. canis (perros)
B. ovis (ovejas)
B. neotomae (ratas del desierto)
B. ceti (delfines, ballenas)
B. microti (zorros)
B. pinnipedialis (focas)
Distribución mundial
países mediterráneos de Europa y África, Oriente Medio, América Central y América del Sur, Asia Central, La India y Mex.
Mexico 25 caos por 100,000
Causa importante de
zoonosis
Representa un riesgo de enfermedad laboral
Granjeros
Veterinarios
trabajadores de mataderos
consumen lácteos no pasteurizados
Transmisión
Hace que vaca aborte, contacto con ternera muerta o consumor productos no pasteurizados de la vaca muerta

Manifestaciones clínicas
Los síntomas de brucelosis son inespecíficos
fiebre ondulante 70/90%
Diaforesis (olor a humedad) 90/95%
Anorexia
cefalea
Linfadenopatía 10-20%
Hepato- esplenomegalia 20-30%
Artralgias 65/70% y lesiones en vertebras
Infección sistémica en la que puede estar afectado cualquier órgano o sistema
GASTROINTESTINAL
70% de los pacientes con brucelosis
Anorexia
Náuseas
vómito}
diarrea.
Puede ocasionar ileítis
También se han reportado casos de pancreatitis (raro)
HEPATOBILIAR
La afectación hepática es frecuente en la brucelosis
Elevación transaminasas.
B. abortus: granulomas similar a sarcoidosis
B. melitensis: cuadros inflamatorios inespecíficos y difusos similar a hepatitis viral.
B. suis da lugar con frecuencia a abscesos hepatoesplénicos.
sacroileitis / espondilitis
vertebras
articulaciones
artritis séptica
meningitis
crónica
pulmón
hasta neumonía lit de todo
Diagnóstico requiere de
Requiere sospecha clínica: fiebre de forma crónica
COMO SE DX
Aislamiento de Brucella en sangre, médula ósea, LCR, etc. Crece lento (6 semanas)
GS es Mielocultivo más sensible que el Hemo (45-90% vs 30-60%) pero no siemopre lo hacemos
Tambien podemos hacer pruebas serológicas:
2 serológicas para la determinación de anticuerpo
una presuntiva y otra confirmatoria
Prueba de tamizaje inicial que debemos de hacer a pacinete que sospechamos que tiene brucella
ROSA DE BENGALA
Prueba de aglutinación, rápida, económica.
Determina anticuerpos IgM, IgG IgA.

Una vez que tienes rosa de bengala positiva se hacen las siguientes pruebas
Cualqueira de las dos

Ya que tenemos esas dos pruebas:

Tratamiento
NO TENENMOS QUE SABER, SOLO SABER QUE HAY 3 ESQUEMAS, SI ES SNC SE PROLONGA TX Y ASI
GI 21 D
DEPENDE TAMBIEN QUIEN ES EL QUE TIENE BRUCELLA



